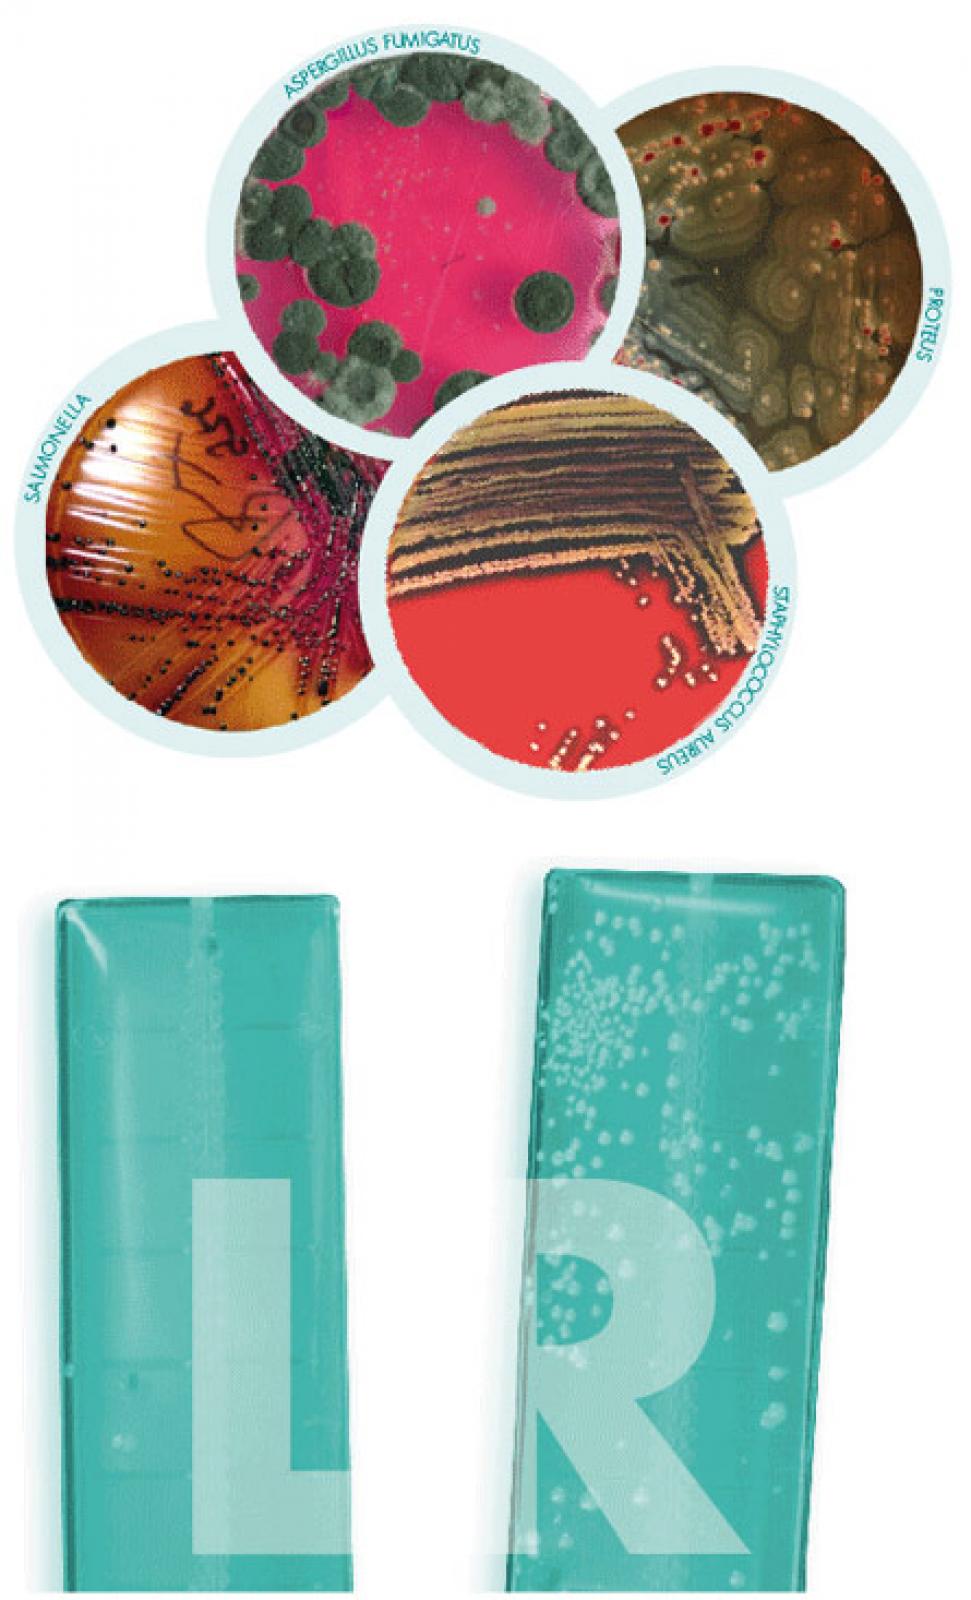

Medizin It und Hygiene
Zahl der Krankenhausinfektionen steigt
INVESTITIONEN ZUR BEKÄMPFUNG VON KRANKENHAUSINFEKTIONEN RECHNEN SICH
Im Krankenhaus erworbene Infektionen sind zu einem weltweit bekannten Problem geworden. Ihre Anzahl steigt und die meist bakteriellen Erreger zeichnen sich zunehmend durch hohe Resistenzen gegenüber Antibiotika aus.
Die Wahrscheinlichkeit, in einem deutschen Akutkrankenhaus an einer solchen nosokomialen Infektion zu erkranken, liegt bei 5,7% bis 6,3%.
So erkranken jedes Jahr 600.000 bis 700.000 Patienten an Infektionen, die sie sich im Krankenhaus zugezogen haben. Die Behandlung solcher Erkrankungen wird durch die zunehmende Multiresistenz der Erreger immer schwerer und aufwändiger.
Bei 1% der infizierten Patienten führt dies ursächlich zum Tod, bei 3-4% trägt die nosokomiale Infektion wesentlich zum letalen Ausgang bei.
Somit ist jede Maßnahme, die eine Reduktion nosokomialer Infektionen bewirkt, eine sinnvolle Investition, sowohl in das Wohl der Patienten, als auch für das Krankenhaus. Denn auch die durch Infektionen verursachten Folgekosten sind enorm:
Bei einer durchschnittlichen Liegezeitverlängerung um 10 Tage bedeutet dies 6,4 bis 7 Millionen zusätzliche Aufenthaltstage mit Kosten von 300 Millionen bis fast 1 Milliarde Euro.
Deshalb stehen Strategien und Instrumente zur Prävention von Infektionen an erster Stelle der qualitätssichernden Maßnahmen im Krankenhaus.
HOHE PRÄSENZ AUCH IN DEN MEDIEN
Das Phänomen der Multiresistenz zeigt sich in vielen Bakteriengruppen. Unter dem Begriff MRE (Multiresistente Erreger) findet man solch kryptische Bezeichnungen wie ESBL (extended spectrum Beta-lactamase)-bildende Arten, MRPSAE (multiresistente Pseudomonas aeruginosa), MRSP (multiresistente Streptococcus pneumoniae), VRE (Vancomycin-resistente Enterokokken) und die verschiedenen Varianten der resistenten Staphylococcus aureus (MRSA, caMRSA, VISA, GISA).
Besonders der Methicillin-resistente Staphylococcus aureus (MRSA) ist Thema in den Krankenhäusern und wird besonders häufig in den Medien diskutiert. Das Suchwort MRSA schafft es bei der führenden Suchmaschine Google® bereits auf über vier Millionen Einträge. Dabei ist MRSA nicht das einzige Risiko.
DIE HÄUFIGSTEN NOSOKOMIALEN KRANKHEITEN:
- Harnwegsinfektionen
- Atemwegsinfektionen
- postoperative Wundinfektionen
- Blutvergiftungen (Sepsis)
- Infektionen des Magen-Darm-Trakts
Patienten infizieren sich besonders häufig bei Operationen mit großen Wunden. Denn dort haben die Erreger besonders leichtes Spiel. Aber auch bei der Aufnahme im Krankenhaus infizieren sich vermutlich schon fünf Prozent.
Der Grund für den Erfolg der Erreger liegt zum Großteil an der übermäßigen und oft unsachgemäßen Verabreichung von Antibiotika in Deutschland in den vergangenen 20 Jahren.
Das Resultat sind Selektion und Generierung von hochresistenten Arten, die sich dann wegen nicht beachteter oder nur fragmentär etablierter Hygienesysteme leicht ausbreiten. Zur Eindämmung der Risikokeime werden schon seit Langem immer empfindlichere Hygienepläne erstellt, kostenintensive Raumluftreinigungsanlagen installiert und gewartet, bauliche Maßnahmen zur Trennung und Abschottung ergriffen. Und trotzdem steigt die Anzahl der Infektionen weiter.
TEURE GÄSTE IM KRANKENHAUS
Vom unnötigen Leid der Menschen abgesehen gibt es weitere Gründe, die alle Anstrengungen zur Verhinderung einer MRE-Kontamination rechtfertigen: Die Kosten und das Image.
Heute werben Kliniken in Qualitätsberichten damit, dass ihre POI-Rate unter Bundesdurchschnitt liegt. Viele Infektionen sind meldepflichtig und werden statistisch erfasst und veröffentlicht.
Weiterhin kommen die Krankenkassen unter den geltenden DRG-Bedingungen nicht für die Kosten auf, die durch die verlängerte Behandlung und/oder Sanierung infizierter und kolonisierter Patienten entstehen.
Sie liegen selbst bei gut genesenden Patienten schnell bei ca.10.000 Euro.
DER VEKTOR HAND
Auch die unbelebte Umwelt ist nicht frei von Mikroorganismen. Oberflächen im Krankenhaus dienen vielen Bakterien als Depot, von dem aus sie auf andere Areale durch Vektoren übertragen werden.
Auf diesen Oberflächen können Bakterien lange Zeit überleben. Für MRSA stellen vier Wochen kein Problem dar.
Der wichtigste Vektor ist der Mensch und dort wesentlich seine Hand. Ein „Areal“, auf das die Übertragung zielt, kann ein Patient sein oder auch ein weiterer Krankenhausmitarbeiter, der dann ebenfalls Personen infizieren kann.
So wird eine Kaskade in Gang gebracht, die nach kurzer Zeit zu einer massiven Ausbreitung der Erreger führt, mit dem Ergebnis zunehmender Infektionsraten. Verhindert werden kann ein solches Szenario durch geeignete Desinfektionsmaßnahmen von dazu vorgesehenen Spezialoberflächen und Händen.
Der Vorstand des DGKH, Prof. Dr. Walter Popp, erhebt dazu öffentlich folgenden Vorwurf:
» Berlin: Jährlich sterben mindestens 20.000
Patienten in Deutschland nur deshalb, weil sich das Personal nicht ausreichend die Hände wäscht. Diesen Vorwurf hat Walter Popp, Vorstand bei der Deutschen Krankenhaushygiene, gegen die Hospitäler und die Bundesländer als zuständige Aufsicht erhoben. «
Quelle: Tageszeitung Rheinische Post vom 14.03.2008
Daraus lässt sich ableiten, dass alle Handkontaktflächen, die nicht gut desinfizierbar sind, zur Kreuzkontamination beitragen.
MRSA UND IT
Es ist bekannt, dass sich MRSA in der unbelebten Umgebung (z.B. auf Handkontaktflächen) des Patienten und des Personals nachweisen lassen.
Auch auf Computertastaturen wurde MRSA nachgewiesen. Gerade herkömmliche Computertastaturen stellen eine Besonderheit dar.
Durch ihre Konstruktion weisen sie viele vertikale und horizontale Flächen sowie nicht erreichbare Schlitze auf, was einhergeht mit einer äußerst komplizierten Situation, wenn es um die Flächendesinfektion geht. Sie stellen einen Sonderfall unter den schwierig zu reinigenden/desinfizierenden Handkontaktflächen dar.
Seitens der Hygiene gilt daher die Forderung, dass in Risikobereichen patientennahe Flächen und Flächen mit häufigem Handkontakt desinfizierbar sein müssen, besonders für IT-Komponenten und -Systeme.
Es genügt nicht, die Kontamination der unbelebten Umgebung durch die Hände des Pflegepersonals primär organisatorisch, bzw. durch konsequente Einhaltung der Händedesinfektion/Händehygiene zu regeln.
Nur die ebenfalls vorgenommene Desinfektion der Kontaktflächen, hier von Computertastatur und Eingabegeräten, verspricht Erfolg.
HYGIENE UND IT-SYSTEME
Nicht allein Computertastaturen und Eingabegeräte wie PC-Mäuse können zum Hygienerisiko werden. Auch die Systeme und Monitore sind hygienisch relevant.
Herkömmliche Computer und Monitore weisen neben Spalten, Ritzen und offenen Verschraubungen Lüftersysteme auf. Es konnte gezeigt werden, dass diese neben Staub auch Mikroorganismen ansaugen und im Inneren des Systems akkumulieren.
Durch die besondere Fähigkeit, oft lange Zeiten auf trockenen Oberflächen keimfähig zu überleben, können so potente Infektionserreger angereichert und in großer Keimzahl in die Umgebung freigesetzt werden.
Handelt es sich bei der Umgebung um einen Operationssaal, eine Intensivstation, eine onkologische Station, oder auch eine Sterilisationsabteilung, muss dies als infektiologisch höchst riskant eingeschätzt werden.
Daher werden auch PC-Systeme und Monitore als kritisch eingestuft. Sie müssen leicht desinfizierbar sein und sollen keine „Keimschleudern“ darstellen. Erreichbar ist dies durch Schaffung geeigneter Oberflächen und den Verzicht auf Lüftersysteme.
AUS DEM FAQ DES ROBERT KOCH INSTITUTS
Im FAQ der Internetpräsenz des Robert Koch Instituts fanden wir einen aktuellen Hinweis zum Einsatz von Computern und Tastaturen in kritischen Bereichen:
WAS IST BEIM EINSATZ VON PERSONAL COMPUTERN (PC) UND NOTEBOOKS IM BEREICH DER PATIENTENVERSORGUNG IN EINRICHTUNGEN DES GESUNDHEITSWESENS ZU BERÜCKSICHTIGEN?
Hier zwei Zitate aus dem FAQ des RKI:
» Daraus kann gefolgert werden, dass der Einsatz von Hardware ohne Lüfter (Gebläse) in kritischen Bereichen (OP, Intensivstation) zu empfehlen ist. Dies ist die rationale Ableitung aus den o. g. Überlegungen. Studien oder andere Beobachtungen zu nosokomialen Infektionen durch solche Gebläse wurden bisher nicht veröffentlicht. «
» Herkömmliche Tastaturen sind ob ihres komplizierten Aufbaus in der Regel nicht zu desinfizieren. Es muss rasch mit Defekten gerechnet werden. Um dort glatte, flüssigkeitsdichte Flächen mit der Möglichkeit der Desinfektion anzubieten, sind Hersteller bereits tätig geworden. Es kann also hier nur empfohlen werden, Geräte mit einer entsprechenden Konstruktion anzuschaffen. «